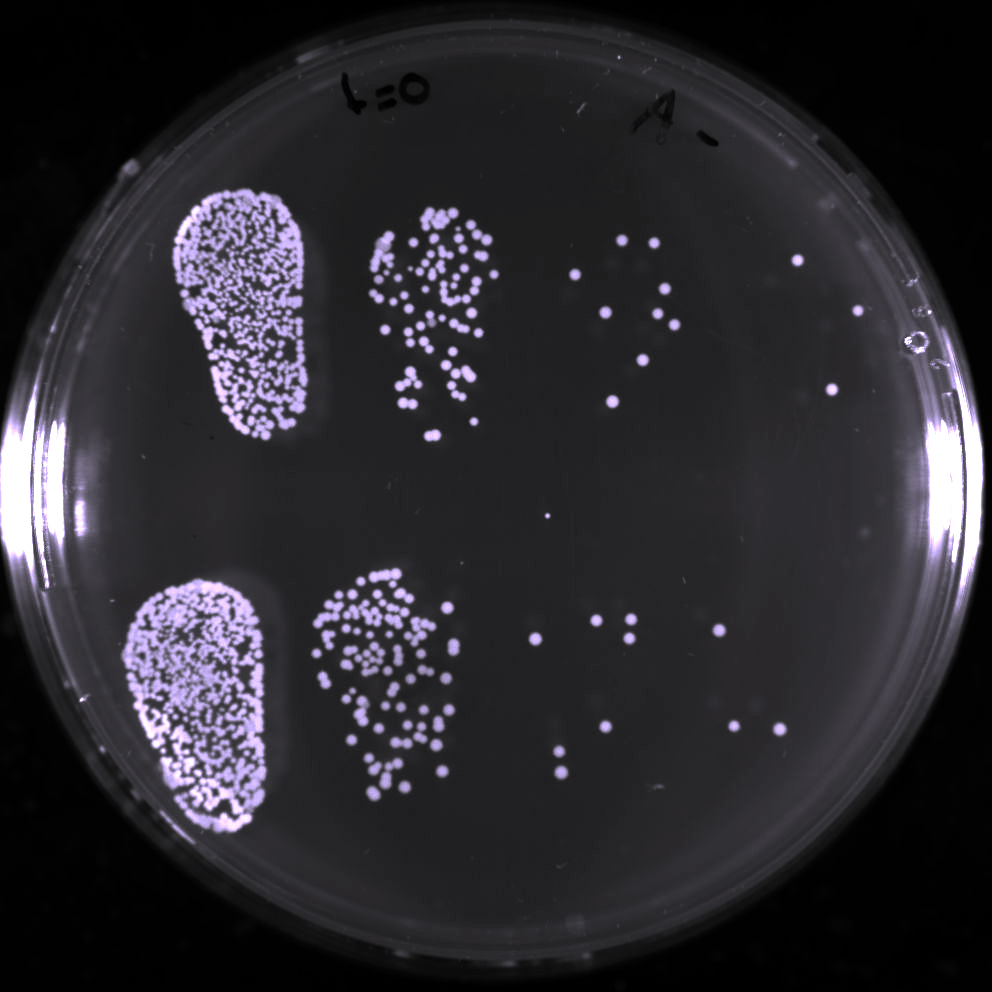

Туберкулез- это болезнь, которая вызывается микобактерией. М. tuberculosis . длинные (1.3,5 мкм), тонкие (0,2.0,4 мкм), слегка изогнутые палочки, грамположительные, неподвижные, спор и капсул не образуют. При микрокультивировании на стеклах в жидкой среде через 3 сутки образуются микроколонии, где вирулентные микобактерий располагаются в виде кос и жгутов. Этот феномен называется корд-фактором.
Как правило, туберкулез поражает легкие, но в редких случаях может затрагивать другие части тела, например лимфатические узлы, костную систему и даже мозг. Туберкулез распространяется от человека к человеку воздушно-капельным путем через кашель, чихание, разговор и при прочем тесном контакте с больным туберкулезом.
- Высокая устойчивость к факторам внешней среды;
- Устойчивость к высоким концентрациям щелочей, минеральных кислот, спирта, не боится холода;
- Высокая устойчивость к противотуберкулезным препаратом
- Оптимальная температура для их жизнедеятельности около +37 градусов;
- При температуре +23 градуса они остаются жизнеспособными до 7 лет, в высохшей мокроте – до 1 года, на страницах книг – до 3-6 месяцев, на одежде и белье больного – до 4 месяцев;
- Они – аэробы;
- Медленно растут и медленно размножаются. Делятся простым деление или почкование, не образуют спор.
Основным источником заражения человека микобактериями являются люди больные открытыми формами туберкулеза. Т.е. те, которые выделяют бациллы Коха во внешнюю среду. Больной человек вместе с мокротой при кашле, чихании, разговоре выделяют в окружающую среду миллионы бактерий, которые распространяются в воздухе в радиусе 2-6 м, затем осаждаются вместе с пылью на пол, на предметы и могут в течение многих лет оставаться жизнеспособными.
Заразиться туберкулезом можно при тесном общении с больными туберкулезом. Контактное заражение происходит при поцелуе, через носовой платок, постельное белье, через посуду, через одежду и другие вещи, на которые попала мокрота, содержащая большое количество микобактерий.
Заразиться туберкулезом можно и от больных туберкулезом животных как при непосредственном контакте с ними, так и при употреблении полученного от них молока, молочных продуктов и мяса.
Поэтому, выделяют пути заражения микобактериями туберкулеза:
- Аэрогенный (через воздух)
- Пищевой (через продукты питания_
- Контактный (через бытовые предметы)
Туберкулёз лёгких может длительное время протекать бессимптомно или малосимптомно и обнаружиться случайно при проведении флюорографии или на рентгеновском снимке грудной клетки. Факт обсеменения организма туберкулёзными микобактериями и формирования специфической иммунологической гиперреактивности может быть также обнаружен при постановке туберкулиновых проб.
В случаях, когда туберкулёз проявляется клинически, обычно самыми первыми симптомами выступают неспецифические проявления интоксикации: слабость, бледность, повышенная утомляемость, вялость, апатия, субфебрильная температура (около 37 °C, редко выше 38°), потливость, особенно беспокоящая больного по ночам, похудение. Часто выявляется генерализованная или ограниченная какой-либо группой лимфатических узлов лимфаденопатия — увеличение размеров лимфатических узлов. .
Далее по ходу развития заболевания присоединяются более или менее явные симптомы со стороны пораженного органа. При туберкулёзе лёгких это кашель, отхождение мокроты, хрипы в лёгких, насморк, иногда затруднение дыхания или боли в грудной клетке (указывающие обычно на присоединение туберкулёзного плеврита), кровохарканье. При туберкулёзе кишечника — те или иные нарушения функции кишечника, запоры, поносы, кровь в кале и т. д. Как правило (но не всегда), поражение лёгких бывает первичным, а другие органы поражаются вторично путём гематогенного обсеменения. Но встречаются случаи развития туберкулёза внутренних органов или туберкулёзного менингита .
Не нашли то, что искали? Воспользуйтесь поиском:
Презентация к уроку
Внимание! Предварительный просмотр слайдов используется исключительно в ознакомительных целях и может не давать представления о всех возможностях презентации. Если вас заинтересовала данная работа, пожалуйста, загрузите полную версию.
Цель:
- познакомить учащихся с информацией об основных бактериальных заболеваниях человека,
- продолжить формирование понятия и правил здорового образа жизни
Задачи:
- Выяснить, как попадают болезнетворные бактерии в организм человека
- Какие особо опасные болезни вызывают бактерии
- Каковы основные меры борьбы с болезнетворными бактериями
- Как защитить свой организм от болезнетворных бактерий
- Оборудование: медиапроектор, презентация ppt
План
1. Бактериальные болезни человека
2. Ботулизм — возбудитель, пути заражения, меры борьбы
3. Дизентерия — возбудитель, пути заражения, меры борьбы
4. Столбняк — возбудитель, возможность заражения, профилактические меры борьбы
5. Сибирская язва — возбудитель болезни, пути заражения и меры профилактики
6.Туберкулёз — возбудитель болезни, пути заражения, меры профилактики
7. Хеликобактер пилори — возбудитель заболевания, возможности заражения, профилактика
8. Холера — возбудитель болезни, пути заражения, меры борьбы
9. Чума — возбудитель болезни, возможные пути заражения, меры борьбы
1. Бактериальные болезни человека (слайд 2)
Количество бактериальных заболеваний человека огромно. На сегодняшний день болезни, вызываемые бактериями, являются самыми опасными, так как они способны не только усугубить качество жизни человека, но и привести к смертельному исходу. Поэтому нам необходимо знать не только возбудителей и симптомы бактериальных болезней человека, но и возможные причины этих заболеваний и возможные меры борьбы с ними. К бактериальным заболеваниям относятся : чума, холера, сибирская язва, туберкулёз, ботулизм, столбняк, ангина, менингит, дифтерия, дизентерия, коклюш, скарлатина, гастрит, язва желудка и этот список можно продолжать ещё и ёщё.
2. Ботулизм — возбудитель, пути заражения, меры борьбы (слайды 3-4)
Возбудитель — клостридия ботулизма, он широко распространён в природе с постоянным местом обитания в почве. Также его можно обнаружить в навозе, фруктах, овощах, рыбе, экскрементах теплокровных животных. Способен образовывать споры, которые очень устойчивы к воздействию химических и физических факторов. Споры способны выдерживать кипячение в течении 5 часов при температуре 120 градусов Цельсия. В среде с малым содержанием кислорода быстро размножаются и образуют опасный токсин(яд). Ботулотоксин- один из известных и сильных ядов. Сам возбудитель не вызывает заболеваний у человека, опасен только его токсин. Для возникновения отравления необходимо размножение возбудителя с накоплением в организме ботулотоксина.
Развивается в результате попадания в организм пищевых продуктов: ветчины, колбасы, солёной рыбы, а также консервированных овощей, фруктов, а особенно грибов. В последние годы случаи ботулизма в России связаны при приготовлении домашними консервированными продуктами. Безопасность «баночек» порой нельзя установить на глаз, ботулотоксин не приводит к изменению цвета, запаха и вкуса пищи. Вздутые консервные банки обязательно уничтожаются.
Ботулизм- тяжёлое токсико-инфекционное заболевание, поражающее центральную нервную систему, преимущественно продолговатого и спинного мозга. Ботулотоксин всасывается в кровь в кишечнике и избирательно поражает разные отделы нервной системы. Возникает паралич дыхательных мышц, мышц гортани, глотки. Известны случаи отравления с летальным исходом.
Развивается отравление очень быстро, появляется тошнота, рвота, схваткообразные боли в животе, жидкий стул. При первых признаках отравления срочно обратиться к врачу.
Чтобы не заразиться ботулизмом необходимо: строго соблюдать правила личной гигиены, для консервирования использовать только тщательно очищенные от грязи овощи и фрукты, грибы. Банки и крышки для консервирования должны промываться, ошпариваться кипятком, просушиваться. Овощи, а особенно грибы, закатанные в банки, приготовленные в домашних условиях категорически запрещается покупать у незнакомых случайных людей.
3. Дизентерия — возбудитель, пути заражения, меры борьбы (слайды 5-6 )
Дизентерия- это инфекционная болезнь, которую вызывает бактерия дизентерийная палочка.
Заражение происходит при попадании в организм возбудителя через рот с пищей, водой или через грязные руки. Переносчиками дизентерийной палочки могут быть мухи. Болеют дизентерией только люди. Источником инфекции может быть больной человек. Инфекция способна распространяться очень быстро.
Дизентерия- болезнь характеризующаяся учащением стула, примесью слизи и крови в кале, схваткообразными болями в животе, повышением температуры тела до 39 градусов и более. Частота стула может доходить до 15-25 раз в сутки и более. Особенно тяжело заболевание протекает у детей. организм ребёнка обезвоживается быстрее, чем у взрослых. Раньше, когда не было антибиотиков от дизентерии люди умирали.
Лечение дизентерии направлено на уничтожение возбудителя и проводится оно в стационаре инфекционного профиля.
Меры профилактики: регулярное и тщательное мытьё рук после туалета, прогулок и перед приёмом пищи, сырых овощей и фруктов, избавляться от мух в помещении, не допускать их контакта с продуктами. Ведь не зря дизентерию называют «болезнью грязных рук».В настоящее время можно делать профилактическую прививку от дизентерии.
4. Столбняк — возбудитель, возможность заражения, профилактические меры (слайды 7-8 )
Столбнячная палочка- микроскопическая бактерия, которая обитает в желудочно-кишечном тракте травоядных животных. Столбняк является острым инфекционным заболеванием человека, в результате которого поражается нервная система, нарушается иннервация скелетных мышц. Вместе с фекальными массами больных животных выделяется огромное количество спор возбудителя. Споры очень стойки к воздействию факторов внешней среды, они могут годами сохранять способность к жизнедеятельности, находясь с почве в состоянии споры.
Заболевание начинается остро. Заболевание сопровождается судорогами скелетной мускулатуры: мышц тела, конечностей, мимических мышц, мышц глотки. В результате сильнейшего тонуса и болезненного состояния мышц спины, то при этом спина больного выгибается дугой. Спазм мышц настолько бывает сильным, что возможны переломы костей и их отрыв от костей.
В организм человека столбнячная палочка проникает через ранки, царапины и другие повреждения на коже. В некоторых регионах столбняк называют «Болезнью босых ног», так как даже заноза в стопе ноги или ржавый гвоздь могут стать воротами для инфекции.
Меры профилактики: Снижение травматизма, особенно при работе с землёй( работать в рукавицах или перчатках), делать профилактические прививки, каждые 10 лет
5. Сибирская язва- возбудитель болезни, пути заражения, меры профилактики (слайды 9 -10 )
Сибирская язва известна с древнейших времён. Её называют злокачественным карбункулом. Возбудителем является бактерия в форме палочки, она обладает способностью к спорообразованию. Способна десятилетиями выживать в почве или в выдубленной коже больных животных. В благоприятных условиях из споры бактерия переходит в активное состояние. Возбудителя сибирской язвы впервые выделил Роберт Кох. До сих пор Сибирская язва встречается в странах Средней Азии, Африки и Южной Америке. Своё название она получила из-за распространения в прошлом в некоторых областях Сибири. Сейчас в России встречается очень редко.
Источником заражения являются больные травоядные животные: овцы, лошади, верблюды, олени, свиньи. Проведение земляных работ, почвенные воды при ливнях и паводках способствуют проникновению спор бактерий в верхние слои почвы, создавая условия для заражения людей и животных. При заболевании поражаются чаще кожные покровы. Диагностика заболевания не представляет трудностей.
Болезнетворные бактерии выделяются во внешнюю среду с мочой животных, слюной, калом, молоком и выделениями из ран. После их смерти остаются заразными их органы, даже шкура, шерсть и кости. Самый распространённый метод заражения- это контакт с больными животными
При сибирской язве чаще поражаются открытые участки тела- руки и лицо. На участке внедрения возбудителя появляется сначала красное пятно, на его месте со временем появляется папула красно-синюшного цвета, которая начинает жечь и чесаться, затем появляется пузырь с жидкостью, при расчёсывании он лопается. Образовавшаяся язва быстро покрывается чёрным струпом. Увеличиваются лимфоузлы. Процесс сопровождается симптомами интоксикации.
Профилактика заболевания проводится в тесном контакте с ветеринарной службой.
6. Туберкулёз — возбудитель болезни, пути заражения, меры профилактики (слайды 11-12 )
Возбудитель заболевания бактерия туберкулёзной палочки(палочки Коха). Палочки туберкулёза устойчивы к факторам внешней среды. В воде они могут сохраняться до полугода. Долго остаются устойчивыми в темноте и в сырости. а при высокой температуре и освещении солнечными лучами быстро погибают.До 20 века туберкулёз был неизлечим Основной источник заражения- бацилловыделитель — это больной человек. Наибольшую опасность представляют больные с открытой формой туберкулёза. Заболевание часто развивается у людей, злоупотребляющих спиртными напитками, также туберкулёз широко распространён у лиц находящихся в местах лишения свободы(тюрьмах, колониях), либо недавно освободившихся. Передаётся воздушно-капельным путём, также возможно внутриутробное заражение.
Основной орган поражения-лёгкие. Есть признаки по которым можно заподозрить туберкулёз — кашель, боли в груди, а также кровохарканье. Диагностируется туберкулёз при прохождении флюорографии.
Основа лечения- применение противотуберкулёзных медицинских препаратов. Длительность лечения зависит от тяжести заболевания. В некоторых случаях прибегают к хирургическому вмешательству. Раньше, когда не были известны антибиотики, люди умирали от туберкулёза и называли эту болезнь»чахотка».Сейчас существует целая область медицины, занимающаяся туберкулёзом — фтизиатрия, а её специалисты-врачи фтизиаторы.
Профилактика туберкулёза заключается в своевременном прохождении флюорографии, отказаться от вредных привычек- курения, особенно алкоголя, правильно питаться, вести здоровый образ жизни.
7. Хеликобактер пилори — возбудитель заболевания, возможности заражения, профилактика
Бактерии Хеликобактер пилори на сегодняшний день являются самыми распространёнными. Более половины населения планеты можно считать переносчиками данной бактерии .Эта бактерия сейчас самая изучаемая в мире. Знать, как выглядят основные признаки заражения бактерией Хеликобактер нужно, чтобы лечение началось своевременно. Обитает бактерия в желудочно-кишечном тракте. Она хорошо чувствует себя в желудке и хорошо приспособлена к агрессивной кислой среде желудка.
Точный механизм заражения пока неизвестен. Есть лишь предположение, что заражение может происходить — через грязные руки и загрязнённую пищу или воду. Заболевание может считаться семейным. Стоит одному из членов семьи заразиться бактерией, то симптомы заболевания появятся у всех остальных членов семьи
Признаки заболевания: проблемы со стулом (либо запоры, либо поносы, изжога, беспричинная тошнота или рвота, неприятный запах изо рта). Заболевание приводит к язве желудка и двенадцатиперстной кишки, гастрит, предрасположенность к раку желудка.
Методы диагностики: гастроскопия с взятием биопсии слизистой желудка, анализ кала, анализ крови на антитела. Существует много способов диагностики, но ни один из них не может считаться абсолютно достоверным.
Меры профилактики: средства личной гигиены должны быть индивидуальными, мыть руки перед едой, не курить, не злоупотреблять спиртными напитками. Прививок от бактерии Хеликобактер пилори пока не создано. Создать вакцину, действующую в кислой среде желудка очень сложно
8. Холера — возбудитель болезни, пути заражения, меры борьбы (слайды 15-16)
Возбудителем холеры является бактерия холерного вибриона. Встречается в открытых водоёмах, сточных водах, может развиваться в мясных продуктах и молоке. По данным Всемирной организации здравоохранения в год в мире заболевают холерой от 3-5 миллионов человек. Являясь высоко заразной, от холеры ежегодно умирает до 1,5 миллионов детей в год. Доказано, что эпидемии холеры возникают в странах с невысоким уровнем жизни. Более 2,5 миллиардов человек на Земле не знают, что такое туалет, не имеют возможности даже мыть руки. Мухи являются переносчиками инфекции. Холера страшное заболевание, которое в своё время унесло миллионы жизней людей. Холерный вибрион поражает органы желудочно-кишечного тракта, в основном стенки тонкого кишечника.
Вода- основной путь передачи инфекции. Заражение происходит через инфицированные продукты питания, предметы обихода, грязную воду. Начинается заболевание внезапно. Боли в животе, частые акты дефекации, жажда, сухость во рту, упадок сил, понижение температуры тела, больной мёрзнет, появляется рвота, падает артериальное давление. В результате происходит резкое обезвоживание. Заболевание лечится с использованием антибиотиков.
Меры профилактики: не пить воду из непроверенных источников, соблюдать правила личной гигиены, тщательно мыть сырые овощи и фрукты.
9. Чума — возбудитель болезни, возможные пути заражения, меры борьбы (слайды 17-18)
Возбудителем заболевания является чумная палочка, которая имеет нежную капсулу и никогда не образует спор, что не позволяет нашим лейкоцитам активно бороться с возбудителем. Более половины населения Европы в Средние века унесла чума, известная как «чёрная смерть». Ужас этих эпидемий остался в памяти людей. Ни одна инфекционная бактериальная болезнь не унесла столько человеческих жизней как чума. В настоящее время данное заболевание остаётся особо опасной инфекцией. Около 2 тысяч человек заражается ежегодно, большая часть больных умирает. Бактерии чумы выделяют очень сильные токсины(яды).Возбудитель очень быстро размножается в органах и тканях организма человека, распространяясь с током крови и по лимфатическим сосудам по всему организму. Палочка бактерий способна даже проникать через неповреждённые кожные покровы. В почве не теряет жизнеспособность до нескольких месяцев и даже лет. В трупах животных живёт до нескольких месяцев. Бактерии чумы устойчивы к низким температурам и замораживанию. Зато чувствительны к высоким температурам, кислой реакции среды, солнечным лучам, которые их убивают за 2-3 часа. Возбудители чумы поражают не только человека, но и животных. Подвержены заболеванию кошки, лисицы, но а большинство составляют грызуны. Переносчиками заболевания являются блохи, паразитирующие на инфицированных грызунах. Опасность для человека представляют крысы, которые живут рядом с жилищем человека. Поэтому одной из мер по предупреждению заражения этим тяжелейшим заболеванием является борьба с грызунами.
10. Вывод (слайд 19)
Да, человека везде подстерегают опасности, у него очень много невидимых врагов, которые стремятся попасть в организм человека. Поэтому мы должны научиться защищаться от них, используя самые элементарные правила личной гигиены- тщательно мыть руки после туалета, перед едой, после улицы, мыть овощи и фрукты перед употреблением, соблюдать все правила термической обработки при консервации продуктов, бороться с насекомыми переносчиками бактериальных инфекций и грызунами, делать профилактические прививки.
Соблюдение этих элементарных жизненных правил поможет вам сохранить здоровье смолоду и на долгие года. Ведь оно не покупается и не продаётся. Бережно относитесь к своему здоровью!

- 11 Февраля, 2019
- Инфекционные болезни
- Валерия Валерия
Бактериальные инфекции наиболее распространены. Они вызывают заболевания различной степени тяжести. Чтобы обезопасить себя от вредного воздействия бактерий, необходимо знать, какие какие болезни человека вызываются бактериями и какие профилактические меры стоит предпринять, чтобы не заболеть.
Бактерии и их классификация

Прежде всего необходимо сказать несколько слов о бактериях. Бактерии есть абсолютно везде. На поверхности кожных покровов человека находятся миллионы таких организмов. В зависимости от формы бактерии делятся на несколько групп:
- кокки– круглые;
- палочки – имеют форму цилиндра;
- спирохеты – спиралевидные.
Палочки размножаются эндоспорами, которые устойчивы к температурным колебаниям.
В зависимости от взаимоотношений с кислородом бактерии подразделяются на аэробные, осуществляющие свою деятельность под воздействием кислорода, и анаэробные – для существования которых кислород не обязателен.
Важную роль играют бактерии в жизни человека. Болезни вызывают патогенные микроорганизмы. В то время как условно патогенные бактерии постоянно находятся в человеческом теле, но не вызывают патологических изменений.
Какие болезни человека вызываются бактериями

Бактерии, попадая в большом количестве в организм, вызывают различные патологии.
Различную степень тяжести могут иметь у человека болезни, вызванные бактериями. Список заболеваний достаточно велик. Стоит перечислить те, которые встречаются чаще всего в медицинской практике:
- туберкулез, возникновению которого способствует палочка Коха;
- пневмония;
- холера;
- чума вызывается палочкой чумы;
- сифилис;
- бруцеллез;
- менингит;
- гонорея;
- брюшной тиф;
- дизентерия;
- сибирская язва;
- сальмонеллез;
- лептоспироз и др.
Это всего лишь небольшая часть болезней, вызываемых бактериями. У человека должна быть крепкая иммунная система, которая позволит предотвратить пагубное воздействие микробов.
Причины бактериальных заболеваний
Болезни от бактерий у человека могут возникать по нескольким причинами. Главной из которых является попадание патогенных микроорганизмов в организм человека. Этому фактору, в свою очередь, способствует снижение защитных функций организма, т.е. иммунитета.
Чтобы возникло заболевание, необходимо большое количество патогенных организмов. Одной или двух бактерий недостаточно для развития инфекции.
Способы заражения бактериальными заболеваниями
Какие болезни человека вызываются бактериями, знают многие люди, а вот способы заражения инфекцией могут назвать далеко не все. Стоит упомянуть об основных путях проникновения микробов в организм:
- Воздушно-капельный. Патогенные бактерии попадают в организм человека во время дыхания, чихания или разговора. Таким образом можно заразиться дифтерией, скарлатиной и коклюшем. Это наиболее частый способ заражения бактериальной болезнью.
- Через пыль. Множество микробов находятся в жизнеспособном виде в пыли. Так может возникнуть туберкулез — одно из самых серьезных заболеваний легких.
- Контактно-бытовой способ — заражение через предметы быта и обихода. Таким образом можно приобрести дизентерию и туберкулез.
- Алиментарный способ, при котором бактерии находятся в воде или на продуктах. Возбудители брюшного тифа и холеры проникают в организм человека именно таким путем.
- Половой. Проникновение болезнетворных бактерий происходит при обмене жидкостями: спермой, слюной, смазкой.
- Трансплацентарный способ, когда инфекция передается от матери к ребенку посредством плаценты. В организм новорожденного ребенка таким способом могут проникнуть возбудители лептоспироза, туберкулеза, сифилиса.
Условно-патогенные бактерии могут вызывать заболевания, если иммунная система очень ослаблена.
Симптоматика бактериальных заболеваний

Симптомы бактериальных инфекций начинают проявляться после завершения инкубационного периода. Стоит сказать об общих признаках, которые сопровождают практически все бактериальные болезни:
- слабость;
- неприятные ощущения во всем теле;
- постоянная усталость;
- боль в мышцах;
- головная боль;
- озноб;
- лихорадка;
- повышение температуры тела выше 38 градусов;
- апатия;
- тошнота;
- общее ухудшение самочувствия;
- сонливость.
Это общие симптомы. Однако в зависимости от типа возбудителя признаки могут различаться. При обнаружении одного или нескольких перечисленных симптомов необходимо незамедлительно обратиться к специалисту в медицинское учреждение для получения квалифицированной помощи. Самолечением заниматься не стоит. Это может усугубить ситуацию и осложнить течение болезни.
Стоит ли использовать антибиотики в борьбе с бактериальными инфекциями

Этот вопрос волнует многих людей, которые считают, что к помощи антибиотиков нужно прибегать в самых крайних случаях. Но как правило, заболевания, вызванные бактериями, нуждаются именно в использовании антибиотиков. Курс приема препаратов подобного типа позволит быстро справиться с болезнью и избежать возникновения осложнений. Не все знают, какие болезни человека вызываются бактериями. Именно поэтому назначить антибиотики может только врач, приняв во внимание особенности протекания патологического состояния.
Лечение

В большинстве случаев в борьбе против бактерий, как мы уже сказали, применяют антибиотики. Благодаря их созданию инфекции, вызванные патогенными организмами, перестали быть опасными для жизни пациента. Их действия направлены на полное уничтожение микроорганизмов. Лекарственные средства способствуют приостановке роста и размножения бактерий. Приниматься препараты могут перорально, т.е. в форме таблеток, или в виде инъекций, т.е. внутримышечно. Последний способ используется реже, в особо тяжелых случаях. Прием антибиотиков может вызывать возникновение аллергических реакций. Поэтому чаще всего помимо данной категории препаратов доктор назначает антигистаминные средства. При сильной аллергии врач принимает решение о замене препарата. В комплексе с антибиотиками принимаются очень часто пребиотики для кишечника, действие которых направлено на восстановление нормальной микрофлоры. Нельзя ни в коем случае прерывать курс лечения. Обязательно необходимо завершить его.

Выздоровление после бактериальной болезни может быть нескольких видов:
- полное, при котором из организма полностью удалены все возбудители заболевания;
- лабораторное, в случае которого выздоровление подтверждается отсутствием патогенных организмов;
- клиническое, при котором полностью исчезают симптомы заболевания.
Если лечение проведено своевременно, то наступает полное выздоровление без развития каких-либо опасных осложнений.
Меры профилактики бактериальных заболеваний
Нужно сказать о нескольких мерах профилактики, которые помогут избежать проникновения патогенных бактерий в организм и снизят вероятность возникновения инфекции:
- Укрепление иммунной системы. Если у человека крепкий иммунитет, то многие инфекционные болезни ему не страшны. Если инфекция все-таки проникла в организм человека с хорошей защитной системой, заболевание будет протекать в легкой форме без каких-либо осложнений.
- Правильное питание. Употребление полезной пищи изо дня в день способствует насыщению организма всеми необходимыми микроэлементами и витаминами. В пищу должны быть включены фрукты и овощи.
- В режим дня должны быть включены прогулки на улице. Комнаты в помещении следует регулярно проветривать.
- Регулярные занятия физкультурой способствуют укреплению организма.
- Соблюдение элементарных процедур личной гигиены также поможет избежать проникновению болезнетворных бактерий в организм человека. Нужно тщательно мыть руки, особенно после посещения больного. Для мытья лучше использовать антибактериальное мыло.
- Нужно избегать контактов с больными людьми. В случае крайней необходимости лучше воспользоваться специальной маской, которую можно приобрести в любой аптеке.
От некоторых опасных заболеваний бактериального происхождения смогут защитить прививки. Их можно сделать в поликлинике по месту прописки. Вакцинация несовершеннолетних проводится в обязательном порядке. На протяжении первого года жизни младенцу делается несколько прививок, в том числе от пневмококковой инфекции.
Заключение
Защитить организм от бактерий — возбудителей болезней человека поможет соблюдение элементарных профилактических мер. В случае проявления первых симптомов своевременное обращение в медицинское учреждение предотвратит возникновение серьезных осложнений. Далеко не все люди знают, какие заболевания человека вызываются бактериями. Только специалист может установить природу патологии и прописать необходимые лекарства.

В статье речь пойдет о холере, возбудитель которой довольно стоек в окружающей среде. Это болезнь, известная человечеству достаточно давно. Причины ее появления были выявлены лишь недавно, чего не скажешь о существовании самого возбудителя. Чума, сибирская язва и холера относятся к особо опасным заболеваниям, которые отличаются высокой контагиозностью, тяжелым течением и высокой смертностью. Сегодня именно они являются основой для создания биологического оружия. И хотя современная статистика не дает оснований для беспокойства, минимальные знания об опасных болезнях и их возбудителях могут быть полезны.
Исторический очерк

Именно с середины 19-го века начались масштабные исследования по определению возбудителя холеры. В Европу инфекция прорвалась с войнами и по торговым путям из Азии и Египта. Именно в Египет отправилась в 1881 году исследовательская экспедиция, в которую входил известный бактериолог Роберт Кох (1843-1910). Именно им были открыты возбудители холеры и туберкулеза (вибрионы и палочки Коха). Робертом Кохом были разработаны и первые профилактические рекомендации в отношении данного заболевания.
В соответствии с перечнем Всемирной организации здравоохранения, бактерии-возбудители чумы и холеры, а также сибирской язвы, отнесены к патогенам, вызывающим особо опасные заболевания.
Пандемии холеры
Последняя пандемия была объявлена в 1962 году. Именно тогда на сцене появился вибрион Эль-Тор. К 1970 году пандемия охватила 39 стран. Она унесла жизни более 40 тысяч человек.
Мировая эпидемиологическая ситуация оставляет определенную настороженность. Так, эпидемия холеры в Японии в июне 1977 года распространилась уже к августу на Ближнем Востоке. Она стала самой большой эпидемией в данном регионе за предыдущие 20 лет. За один месяц холера охватила Сирию, Иорданию, Иран и еще 10 ближневосточных государств.

Рыцари борьбы с холерой
Как уже говорилось, Роберт Кох в 1883 году подробно описал холерный вибрион и симптомы болезни. В том же году будущий лауреат Нобелевской премии по исследованию иммунитета Илья Ильич Мечников (1845-1916) добровольно принял культуру холерного вибриона, чтобы на собственном опыте изучить течение болезни. Удивительно, но он не только выздоровел, но и после болезни у него улучшилось зрение и характер.
Бактерии или вирусы?
Возбудителями холеры являются холерные вибрионы (Vibrio cholerae) – грамотрицательные анаэробные бактерии. Вибрион имеет форму изогнутой палочки и снабжен жгутиком. Возбудитель холеры, микробиология которого изучена довольно хорошо, обладает геномом из двух хромосом и размножается в планктоне пресных и соленых водоемов. Известно более 150 серотипов холерного вибриона. Каждый серотип возбудителя холеры относится к условно-патогенным организмам и отличается по соматическому антигену. В зависимости от серотипа и пути попадания инфекции в организм, отличается и течение ее болезни. Но только два серотипа вызывают симптомы недуга.
Бактерия-возбудитель холеры устойчива при температурах от 16 до 40 градусов, не гибнет при заморозке. Долгое время вибрион проявляет жизнестойкость в водоемах, личных вещах и фекалиях больного. Погибают вибрионы при кипячении, под действием дезинфицирующих средств, содержащих хлор.
Как вибрионы попадают в организм
Что происходит в организме
Бактерии-возбудители холеры являются тропными к тонкому кишечнику человека. Проникнув в организм, холерные вибрионы активно размножаются в тонком кишечнике, повреждают его слизистые оболочки и вырабатывают огромное количество токсинов. Именно токсины (экзотоксины и эндотоксины) вибрионов-возбудителей холеры вызывают нарушения водно-солевого баланса, обезвоживание, нарушение работы нервной системы. Все эти воздействия приводят к судорогам и смерти больного в результате дегидрационного шока. Токсины возбудителя холеры через поврежденные слизистые кишечника быстро попадают в кровоток и вызывают острую интоксикацию и ослабление организма, что повышает риск присоединения вторичных инфекций.
Диагностика холеры
Методы простой микроскопии способны установить наличие возбудителя холеры уже в первые часы заражения. Как это делается?
Классическим методом для определения возбудителя холеры является методика посева на питательные среды. Для анализа берут рвотные массы или фекалии больного. Анализ готов в течении 36-48 часов.
Ускоренные методики не являются достаточно достоверными, а служат лишь подтверждением основной диагностики.

Симптоматика и клиническая картина
Инкубационный период болезни составляет от нескольких часов до 6 дней с момента попадания возбудителя холеры в организм. Начало болезни всегда острое и сопровождается следующими симптомами:
- Частый (до 15 раз в сутки) и жидкий стул. Особенность – это отсутствие зловонного запаха и урчание в животе.
- Тошнота и рвота.
- Острые боли в брюшной полости.
- Повышение температуры до 40 градусов, а затем ее постепенное уменьшение до ощущения постоянного озноба.
- Обезвоживание и чувство жажды.
- Головокружения, слабость.
Лечение болезни
При первых симптомах необходимо срочное оказание медицинской помощи. Больной госпитализируется в инфекционное отделение в отдельный бокс. Лечение направлено на устранение патогена и восстановление водно-солевого баланса в организме. Кроме антибактериальной терапии, назначаются препараты для нормализации работы пищеварительного тракта и восстановление слизистых кишечника. В острой форме предписана строгая диета, в которой преобладают продукты с большим содержанием солей калия. Общий курс лечения длится до 14 дней.

Прогноз может быть положительным только при своевременном стационарном лечении. После выздоровления формируется иммунитет, но только к данному серотипу холеры. Инфицирование другими серотипами вполне возможно.
Профилактика заболевания
Профилактические санитарно-гигиенические мероприятия состоят из государственных и индивидуальных, а также включают в себя вакцинацию.
Среди мероприятий можно выделить следующие:
- Предупреждения занесения холерного вибриона из очагов инфекции.
- Раннее выявление и своевременная изоляция больных.
- Меры по обеззараживанию водоемов общего пользования.
- Обеззараживание питьевой воды.
- Личная гигиена и термическая обработка пищи.
- Применение пероральных вакцин.

Противохолерные вакцины
Первые вакцины появились в 1800-х годах, а пероральные вакцины в 1990-х годах. Вакцина против холеры является базовой в системе здравоохранения и входит в перечень основных лекарственных средств Всемирной организации здравоохранения. Сегодня существует три сертифицированных более чем в 60 странах пероральных вакцины – обычная и модифицированная WC/rBS, и CVD 103-HgR. Все они безопасны, побочными эффектами могут быть понос и умеренные боли в животе. В 85 % их защитное действие длится полгода, в 60 % — до года. Рекомендуется проведение вакцинации лицам с повышенным риском заражения, но они безопасны и эффективны для беременных и лиц с низким иммунным статусом.

Современная ситуация
Статистика Всемирной организации здравоохранения говорит о том, что в мире ежегодно заболевает холерой до 5 миллионов человек, из которых 100 тысяч умирает. Заболевание холерой коррелирует с уровнем жизни и распространено в пятидесяти странах мира. Чем ниже социально-экономический уровень жизни, тем выше риск встретиться с возбудителями холеры и чумы. Высокозаразный холерный вибрион и сегодня активен в Африке, Азии и Индии. Только в 2010 году во время эпидемии холеры в Эфиопии умерло около 8 тысяч человек.
А что у нас?
Вспышка чумы вполне возможна на Алтае. В 2016 году тут заболел десятилетний мальчик, который вместе с семьей разделывал тушки сурков.
А вот на Ямале в 2016 году у 36 человек диагностировали сибирскую язву. Переносчиками стали невакцинированные северные олени.

И вновь продолжается бой
Несмотря на то что в арсенале современной медицины есть эффективные вакцины, действенные антибиотики и сильные средства дегидратации, холера продолжает удивлять своими вспышками. 53 страны мира регулярно посылают отчеты во Всемирную организацию здравоохранения в соответствии с положением о международном надзоре за особо опасными инфекциями. Дает эти отчеты и Российская Федерация.
Читайте также:






